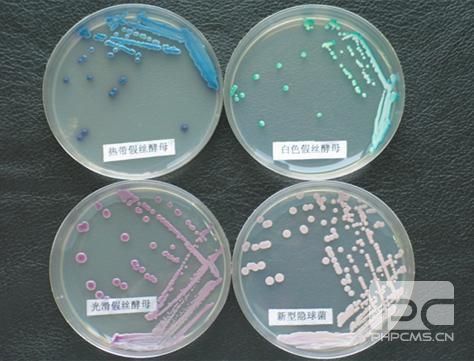

Green-XD生物洗滌除臭設備
工作原理
Green-XD生物洗滌除臭設備是我公司結合國內實際情況,研發出的一套經濟適用,針對凈化各類惡臭氣體的生物洗滌技術。
Green-XD生物洗滌除臭設備的核心為高效生物洗滌器及有利于生物附著和生長的永久性的大表面積生物填料,使微生物在適宜的環境下,在生物填料表面形成生物膜,生物膜中的微生物利用廢氣中的無機和有機物作為碳源和能源,通過降解惡臭物質維持其生命活動,并將惡臭物質分解為水、二氧化碳和礦物質等無臭物,達到凈化惡臭氣體的目的。
Green-XD生物洗滌除臭設備利用多種菌全面降解各污染物
好氧菌 氧菌 兼性菌 化合成細菌 光合成細菌

工藝流程圖如下:

流程說明
管道收集裝置將惡臭氣體送入Green-XD生物洗滌器,洗滌液由霧化噴灑裝置噴灑到生物填料表面,氣流與洗滌液在穿過生物填料層的過程中完成生物的氣液擴散、液固擴散、生物氧化三個過程,生物填料表面生物膜中的微生物以惡臭氣體物質為營養,惡臭物及VOC被微生物氧化分解,在轉化過程中產生能量,微微生物的生長與繁殖提供能源,使惡臭氣體物質的轉化持續進行,經凈化后的氣體由抽風機引出排放。
從填料中流出的洗滌液中含有脫落的生物膜和微生物,經過濾、補充新鮮洗滌液后循環使用,過濾去掉多余的生物膜與溢流液一起排放。
系統特點
Green-XD生物洗滌除臭設備采用水作為生物洗滌液,定時補充,循環使用,運行成本極低;
工藝流程短,輔助設備少,結構緊湊,占地面積小,全自動控制,性能穩定,無須專人操作;
使用永久性生物填料,微生物能夠依靠洗滌液中的養分和氣體中惡臭物質生長,無須另外投入營養液。生物膜生態條件穩定,單位體積內生物量大,微生物菌群具有較高的生物吸附和生物氧化能力,抗沖擊能力強,分解惡臭物質的速度快、效率高;
Green-XD生物洗滌塔體采用玻璃鋼結構,防腐性好,整體性強,便于運輸、安裝;
獨特的氣體分布方式,分布均勻,凈化效率高達90%以上。
適用領域
Green-XD生物洗滌除臭設備適用于:垃圾處理、污水處理、飼料加工、糞便處理等過程產生的含有硫化氫、氨、硫醇、硫醚等惡臭氣體的處理。
技術參數
Green-XD生物洗滌除臭設備機構上分為箱式和塔式兩種形式,可以根據不同安裝環境使用。
Green-XD(箱式)生物洗滌除臭設備主要技術參數

注:Green-XD(箱式)系列設備尺寸僅供參考,實際數據視廢氣性質和現場情況進行優化設計。
Green-XD(塔式)生物洗滌除臭設備主要技術參數

注:Green-XD(箱式)系列設備尺寸僅供參考,實際數據視廢氣性質和現場情況進行優化設計。